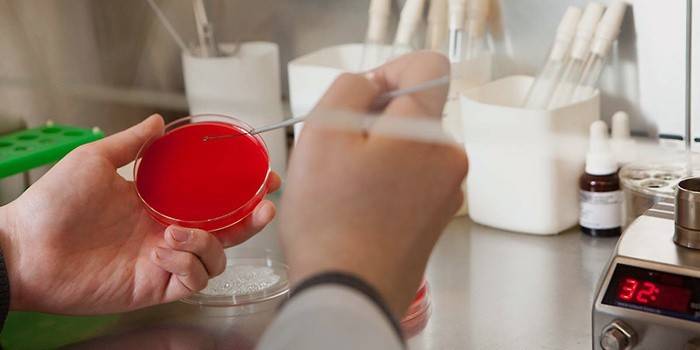

Známky kvapavky u mužov
K infekcii kvapavky dochádza pri pohlavnom styku. Príčinou tohto ochorenia je gonokok. Nebezpečné sexuálne prenosné ochorenie postihuje močovú trubicu, steny konečníka, hltana a oči. Keď sa kvapavka aktívne rozvíja, príznaky u mužov sa objavujú 3-4 dni po nechránenom pohlavnom styku. Po prečítaní tohto článku sa dozviete všetky príznaky, ktoré naznačujú prítomnosť infekcie. Získané informácie pomôžu sformulovať všeobecnú predstavu o chorobe a naučia sa, ako prijať vhodné opatrenia, keď sa objavia prvé príznaky.
Ako sa kvapavka prejavuje u mužov
Nebezpečné pohlavne prenosné ochorenie súčasne postihuje mnoho orgánov a systémov mužského tela. Asymptomatický vývoj infekcie je veľmi zriedkavý, iba v 10% prípadov. Dôvod tohto spočíva v antibiotikách. Silné farmaceutické lieky vedú k zmene biologických vlastností gonokokov, čo vedie k transformácii chorobného procesu. Čo sa týka otvoreného vývoja infekcie, je sprevádzaná množstvom symptómov, ktoré nemožno prehliadnuť. Každá sexuálne aktívna osoba by o nich mala vedieť.

Prvé príznaky
Po inkubačnej dobe 2 - 5 dní sa u mužov objavia prvé príznaky kvapavky. Lézia sa spravidla začína orgánmi genitourinárneho systému. Najbežnejším prejavom choroby je kvapavka močovej trubice. Navyše u mnohých mužov sa 5. až 7. deň po infekcii zvýši teplota a mierne zhorší ich pohoda. Nie vždy je možné rýchlo identifikovať chorobu a predpísať účinnú liečbu. Vo väčšine prípadov muži vyhľadávajú pomoc lekárov, keď sa objavia rušivejšie príznaky.

Pridelenia od člena
Vývoj hnisavej uretritídy sa prejaví po 3 až 4 dňoch. Objaví sa biely hnisavý výtok z penisu. V niektorých prípadoch sa sliznica kvapavky stáva žlto-zelenou farbou. Hnisavá látka, ktorá signalizuje prítomnosť nebezpečnej pohlavnej infekcie v tele, sa spontánne objaví na spodnom prádle alebo sa objaví, keď je na hlavu vyvíjaný tlak. Muž, ktorý zistil žltý alebo biely výtok z penisu, by mal okamžite ísť do nemocnice. Čím rýchlejšie zasahujú špecialisti, tým ľahšie bude liečiť nebezpečnú chorobu.

V ústach
Po orálnom sexe s infikovaným partnerom ovplyvňujú gonokoky dutinu ústnu. V takýchto prípadoch sa u infikovaného človeka vyvinie kvapavka hltana / stomatitída. U homosexuálov sa tieto komplikácie spravidla pozorujú. Faryngitída je vo väčšine prípadov asymptomatická, ale niekedy sa u pacientov vyskytnú nepríjemné pocity v krku a sťažujú sa na nadmerné slinenie. Môže sa vyskytnúť aj ťažké prehĺtanie. Kvapavka na krku nespôsobuje spočiatku značné nepohodlie, ale nemožno ju ignorovať, inak budú následky depresívne.

Príznaky chronickej kvapavky
S rozvojom chronickej kvapavky sú u mužov akútne príznaky. Procesy zápalu sa rozvíjajú nepostrehnuteľne, ale niekedy sa stav zhoršuje. Každé takéto ohnisko vedie k zmene štruktúry postihnutých orgánov. Okrem iného existuje takmer vždy charakteristický príznak, ktorý naznačuje chronickú kvapavka - „syndróm rannej kvapky“. Po nočnom spánku sa pri otvorení močovej trubice objaví malé množstvo zakalenej látky, v ktorej je hnis viditeľný. Zanedbané formy chronickej kvapavky spôsobujú bolesť počas močenia.
Diagnóza choroby
Proces identifikácie kvapavky zahŕňa širokú škálu aktivít. Najprv lekári vezmú na vedomie sťažnosti muža, ktorý hľadá pomoc, a potom vykonajú zložité laboratórne testy. Ak má špecialista podozrenie na kvapavka, pošle pacienta, aby študoval výtok z močovej rúry. Na tento účel sa použije náter na kvapavka. Štúdia vzoriek močovej trubice odhalila patogény kvapavky s pravdepodobnosťou asi 90%.
Maximálna spoľahlivosť štúdie poskytuje techniku sejby mikroflóry vylučovania pohlavných orgánov. Materiál odobratý na analýzu sa umiestni do špeciálneho živného média vhodného na život mikroorganizmov. Laboratórni odborníci niekoľko dní sledujú vývoj flóry a na základe získaných informácií urobia konečnú diagnózu.
Video: čo je kvapavka u mužov
Toto video obsahuje užitočné informácie o procese prenikania gonokokov do tela a ich ďalšom vývoji. Po jeho preskúmaní zistíte, aké nebezpečné môžu byť kvapavky, príznaky choroby u mužov. Tieto informácie vám pomôžu chrániť sa pred bežným problémom - nekontrolovaným vývojom choroby v dôsledku neznalosti.
 Kvapavka - definícia, príčiny, spôsoby infekcie, inkubačná doba
Kvapavka - definícia, príčiny, spôsoby infekcie, inkubačná doba
